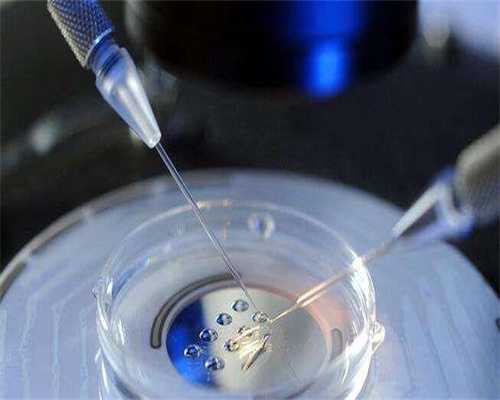
代孕哪家成功率高,原理、准确率、费用...多方面了解精子分离术

济南三代试管包生男孩流程一览!
济南三代试管包生男孩流程一览!试管婴儿技术是近年来发展迅速的辅助生殖技术之一,而三代试管包生男孩则是在传统试管婴儿技术基础上进行优化和改进,能够满足一些家庭对于生育性别的需求。今天我们就来详细了解一下济南三代试管包生男孩的流程。
一、患者评估:确定合适的治疗方案

在接受三代试管包生男孩治疗前,需要先进行全面的患者评估,包括夫妻双方的身体状况、孕育史、生育意愿等。同时还要通过一系列的检查来确保患者的身体状况符合试管婴儿治疗的要求,如血液、生化学、遗传等检查。
二、卵子采集:获取优质卵子
在确定了适宜的治疗方案后,女性需要接受卵巢刺激剂的系列治疗,使卵巢产生多个排卵泡。随后,医生将通过B超定位和穿刺技术,获取优质卵子,在体外与精子结合,完成受精过程。
三、PGD检测:筛选出男性胚胎
在三代试管包生男孩的过程中,需要对受精卵进行PGD(Pre-implantation Genetic Diagnosis)检测,主要用于筛选出性别为男性的胚胎。该技术可以对受精卵的遗传物质进行分析,识别出男性或女性的基因信息,从而确保选择的胚胎性别符合家庭的需求。
四、胚胎培养:培育健康的胚胎
经过PGD筛选出男性胚胎后,需要将其进行培养,使其发育成为健康的胚胎。医生会利用一系列的培养液和仪器,模拟孕育环境,帮助胚胎顺利发育,达到植入子宫的条件。
五、胚胎移植:成功植入子宫
胚胎培育完成后,医生会根据患者的身体状况和治疗方案,将胚胎植入到子宫内部。这是整个三代试管包生男孩的关键步骤。如果植入成功,胚胎将在子宫内继续发育,终成为一个健康的男性婴儿。
济南三代试管包生男孩流程一览!三代试管包生男孩虽然能够满足一些家庭的需求,但也存在一定的风险和不确定性。因此,在接受该项治疗之前,患者需要充分了解该技术的原理和过程,同时还要多方面了解医院和医生的资质和服务质量,以确保终达到满意的治疗效果。





![<strong>[好孕]兰州子宫什么情况不能做试管婴儿</strong>](https://img.btjdy.com/y245s14/btjdy_com/2025/11/27/18/5a56cf4d682406a26b0a7fd491ab569b.jpg)